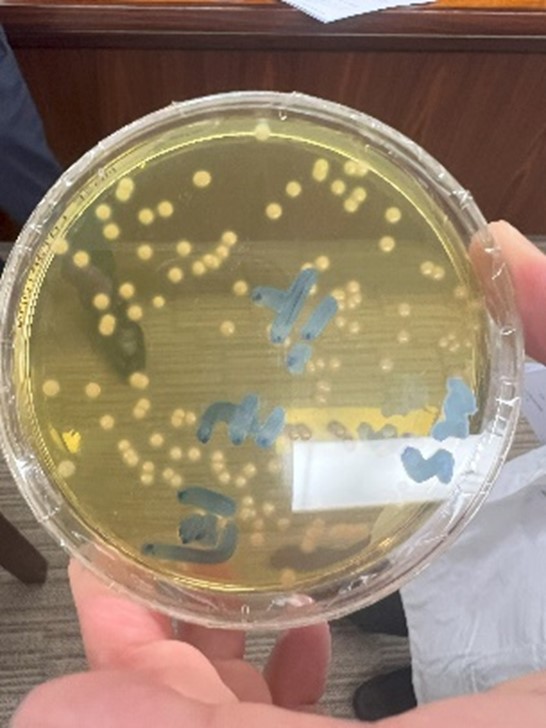

ブログ
4.232026
「4月20日、食肉科学技術研究所を見学しました!」 ねこブロガー ฅ(ↀᴥↀ)ฅ
食肉科学技術研究所(以降、食肉科研という。)の業務内容は、
①農林水産大臣の登録認証機関として、JAS法に基づきハム・ソーセージ・ベーコン・ハンバーグ・ミートボール・大豆ミート食品等を製造する工場の認証とその工場調査等を実施している。
②厚生労働大臣の認可を受けた登録検査機関として輸入食品の検査を行う。
③広く一般からの依頼で、お肉のおいしさ評価など食品検査を行う。
これら食肉や食肉製品などの検査を専門とする団体で、その成果を業界にフィードバックしています。
私たちは、検査室と分析室の見学と微生物検査及び理化学検査と官能検査体験を経験しました。培養に培養を繰り返し、検査に数日かかるものや、調べたい項目ごとに検査があり、なかなか大変そうでした。私が検査員だったら途中で忘れてしまいそうです・・・。

微生物検査室では、トンネルのような窓があり、廊下側の扉を開けて物を置く。そして扉を閉めると、部屋側の人が扉を開いて物を取る仕組みになっています。

理化学検査では、食肉・食肉製品の肉質や品質に関わる検査や食肉の安全性に係る検査を行っていて、数人の検査員が作業に集中していました。
〇食肉・食肉製品の肉質や品質に関わる検査



〇食肉の安全性に係る検査



高そうな測定機器があちらこちらにありました。なんでも25メートルプールに1滴落としただけでもそれが何かを測定できるんだとか!凄すぎる!!!

最後の官能検査体験は、五味識別テストです。
甘味(ショ糖)、塩味(食塩)、酸味(酒石酸)、苦味(無水カフェイン)、旨味(グルタミン酸ナトリウム)の5つの味を当てる検査です。
コップに入ったそれぞれを一つ選び口に含んで味を確かめては水で口をすすぎます。それを繰り返すこと5回、一番難しかったのは甘味のような気がします。
他は、すぐにわかったので自ずと残ったものが甘味となります。再度を口に含むと間違いなく甘味でした。答え合わせの結果は満点でしたよ!

味と香りの違いとは?
食べているときには味と香りを区別していないのですが、鼻をつまんだり開いたりすると区別できるそうです。キャンディで試してみました。鼻をつまんでレモンキャンディを食べると甘さ(味)だけを感じます。そしてつまんでいた鼻を開くとアラ不思議!レモンの香りが鼻を抜けていきます。

実際に拝見し、関心がより一層深まったことをお伝えしたいと思います。
検査というものは、規定要求を満たしていれば『適合品』となりますが、満たしていなければ『不適合品』となります。食品への信頼確保に貢献していると感じました。
このように、この日1日、大変貴重な体験をすることができました。
見学の機会をいただけましたことを食肉科研のみなさまに感謝申し上げます。
「ともだちんちの犬猫コンビ❤」 ねこブロガー ฅ(ↀᴥↀ)ฅ
犬は、ゴールデンレトリバーのヨモギちゃん9才の雌と猫は、ラグドールのワラビくん2才の雄のご紹介です。先輩犬のゴールデンレトリバーのツクシが旅立ってからヨモギちゃんは寂しそう・・・。けど、猫のワラビくんの可愛さに癒されています❤
この子は、ハーネス使って外をお散歩する猫ちゃんなのです!(普通、飼い猫はお外をお散歩しませんよね。)可愛いし、珍しいのでよく声をかけられるそうですよ。




次回は、大阪にある住吉大社の商売発達・家内安全「初辰まいり」で集めた小猫、中猫、大猫を公開します❤
AーOTF-UD新丸ゴPr6N-L00000060OK.png)
